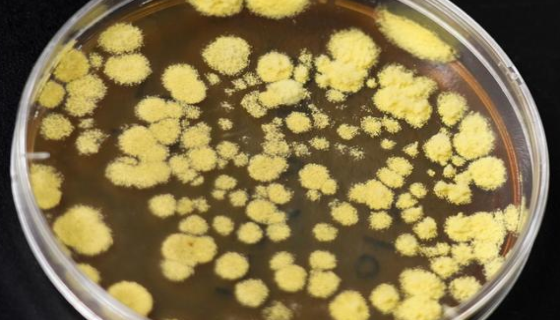
冠突散囊菌的培养方法与使用范围！
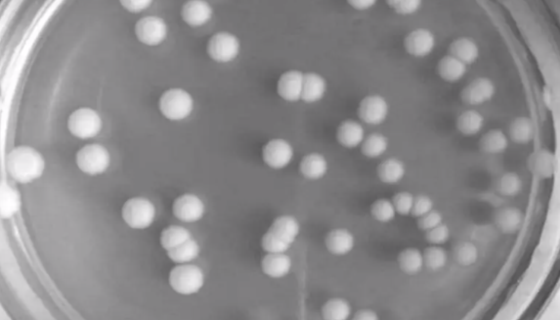
发酵毕赤酵母的特征与价值及注意事项！
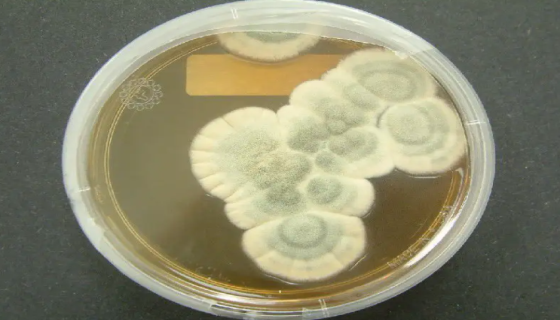
ATCC 28089 产黄青霉冻干管打管说明书！
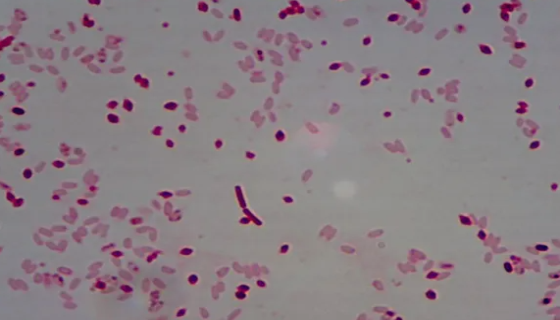
苏云金芽孢杆菌的作用机理与应用领域及使用方法！
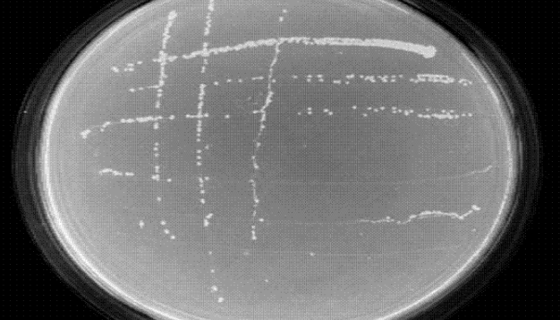
埃氏慢生根瘤菌的知识简介及冻干管打管说明！

冠突散囊菌的培养方法与使用范围!
冠突散囊菌一般指金花(散囊菌目发菌科植物)是对人有益的酵素类...

约氏乳杆菌——用于益生菌类保健食品生产
约氏乳杆菌细胞杆状,通常规则。化能异养菌,需要营养丰富的培养...
发酵毕赤酵母的特征与价值及注意事项!
发酵毕赤酵母,较大;凸起表面细粒;较湿;灰白色;无光泽;边缘...

帚状曲霉的培养方法与注意事项及打管说明!
帚状曲霉的知识解析及冻干管打管说明书。

热带假丝酵母的生存环境及检查与培养方法!
热带假丝酵母即热带念珠菌,是常见的假丝酵母。菌种的鉴别需依靠...
ATCC 28089 产黄青霉冻干管打管说明书!
ATCC 28089 产黄青霉冻干管打管说明书!微生物菌种查...
苏云金芽孢杆菌的作用机理与应用领域及使用方法!
苏云金芽孢杆菌的作用机理与应用领域及使用方法!微生物菌种查询...

GT1-1 小鼠垂体瘤细胞的处理方法与培养步骤!
GT1-1 小鼠垂体瘤细胞的处理方法与培养步骤!微生物菌种查...
埃氏慢生根瘤菌的知识简介及冻干管打管说明!
埃氏慢生根瘤菌的知识简介及冻干管打管说明!微生物菌种查询网是...